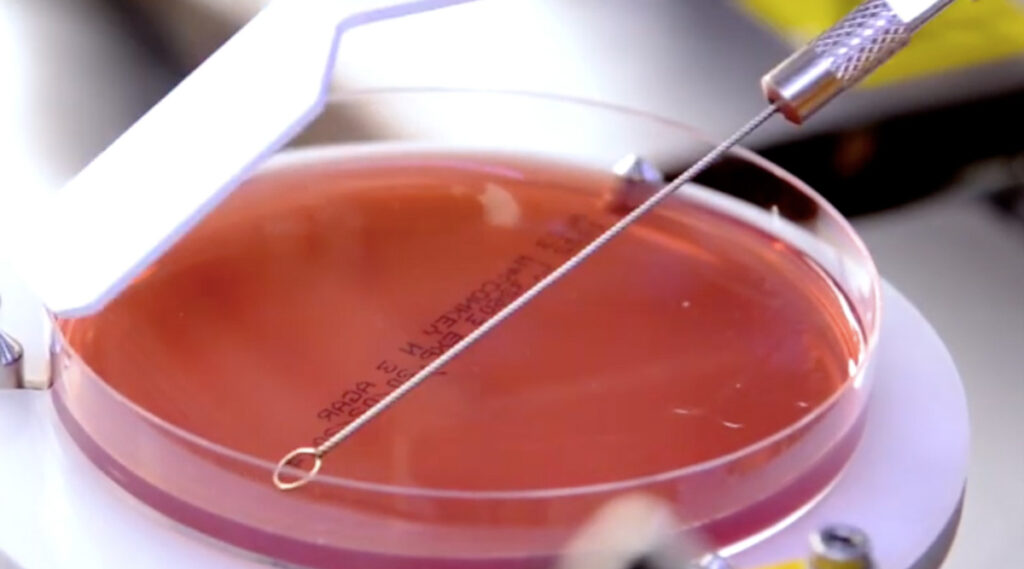

- News
- Diagnóstico
Categorías:
No va de automatizar, va de generar valor a través de la automatización
Tal y como se pronosticó hace más de una década, la microbiología clínica ha sufrido una relativa transformación integrando soluciones de automatización de laboratorios. A pesar de las dificultades que una disciplina tradicionalmente manual y de gran variabilidad pudiera implicar, la aparición de nuevas soluciones en automatización (AUTOPLAK, MALDI-TOF, VersaTREK, …) ha generado indudables mejoras que han repercutido tanto en la calidad y agilidad de los resultados como en la optimización de los flujos de trabajo.
La nueva utilidad que la automatización de laboratorios debe cumplir
Adicionalmente, una de las lecciones que está dejando la actual pandemia es mostrarnos las limitaciones actuales y convencernos de que la automatización de procesos en los laboratorios es clave para poder asumir situaciones futuras como las que estamos viviendo.
Esta lección, en consecuencia, ofrece un nuevo ciclo de oportunidades para consolidar la transformación de esta tipología de laboratorios, exigiendo a empresas, centros de investigación y entidades un nuevo enfoque y mejores herramientas / técnicas que permitan ofrecer mejor servicio a los pacientes y optimizar los flujos de trabajo, en definitiva, aportar mayor valor.
A pesar de que la idea de automatizar un proceso siempre es atractiva, permitiendo al técnico dedicarse a tareas de mayor valor añadido, optimizando costes operativos, incrementando la eficiencia del laboratorio, mejorando la calidad y tiempos de entrega de los resultados… existen numerosos y sonados fracasos.
Como suele decirse:
“Si automatizas un mal proceso, obtienes un mal proceso automatizado”.
Es preciso, entonces, matizar ciertos conceptos y diferenciar entre automatización y generación de valor a través de la automatización de laboratorios.
Conceptualmente:
“La automatización consiste en usar la tecnología para realizar tareas casi sin necesidad de las personas.”
“La creación de valor es la capacidad que tienen las empresas o sociedades para generar riqueza o utilidad.”
“La forma más fácil de medir esa generación de valor es, desde luego, en términos económicos”
Si partimos de las definiciones anteriores y, aunque quizás de manera simplista, una automatización de laboratorios óptima sería “aquel proceso que permite realizar una tarea sin prácticamente interacción humana, generando un servicio de utilidad (y en ciertos casos, un consecuente rendimiento económico)”.
¿Estaríamos de acuerdo con esta descripción?
Un enfoque centrado en el servicio al paciente frente a otros indicadores
Como decíamos, la pandemia ha llegado en un momento de automatización parcial de los laboratorios de microbiología, mostrando sus carencias y demostrando que algunas de las soluciones existentes han dejado de ser completamente de utilidad por sí solas y demostrando que el rendimiento económico debe ser un indicador adicional, no troncal.
Las soluciones totalmente automatizadas (TLA) se han mostrado óptimas, aunque algo independientes y poco interconectables con terceras soluciones, los procesos semiautomatizados se han demostrado cuellos de botella que afectan significativamente al tiempo de respuesta al diagnóstico, algunos procesos tradicionalmente complementarios y manuales se han convertido en troncales en los flujos de trabajo del laboratorio…
Este nuevo paradigma debe hacernos reflexionar y, consecuentemente, hacernos matizar el concepto “nueva utilidad” en el campo de los laboratorios de microbiología clínica.

Automatización holística, dando alcance a todo el flujo de trabajo
Esta nueva manera de entender la “nueva utilidad” obliga a que las nuevas soluciones, aquellas que deben acabar de consolidar la transformación en automatización de esta tipología de laboratorios, deben:
1- Centrarse en el servicio al paciente, frente a otros indicadores
2- Tener una aproximación más holística, integrando de manera inteligente a todas las partes interesadas.
3- Establecer flujos de trabajo que consoliden los procesos preanalíticos, analíticos y post analíticos y ver el proceso en su conjunto, permitiendo que el objetivo de la automatización aporte valor a lo largo de todo el ciclo de trabajo.
4- Priorizar las propuestas modulares, tanto en instrumentos como en consumibles, fomentando la interconexión entre sistemas, aun siendo soluciones de distintos proveedores.
5- Mejorar los procesos no solo dentro del laboratorio si no también con relación al resto de los servicios del centro médico, integrando la mayor cantidad de parámetros del paciente en el proceso de automatización del diagnóstico
6- Ser sostenibles, teniendo en cuenta la minimización en el uso de recursos como el espacio, la energía y los residuos
7- Deben trabajar en la integración de las nuevas técnicas moleculares (T2 Biosystems, Accelerate Diagnostics, …) a los sistemas y flujos de trabajo tradiciones. Su aportación al objetivo final de agilizar el diagnóstico es clave y complementario a los flujos tradicionales.
8- Aceptar el uso de inteligencia artificial como un soporte en el diagnóstico, liberando a los especialistas de tareas repetitivas para que puedan dedicarse a tareas de mayor valor para el paciente
Combinar todos estos objetivos no es siempre fácil, incluso frecuentemente muy complejo, aunque sí debe ser el reto que los actores que nos dedicamos a la automatización de procesos de laboratorio debemos batir.

It is about adding value through automation

¿Deseas hablar con un experto en automatización de laboratorios? Contacta con nosotros >





